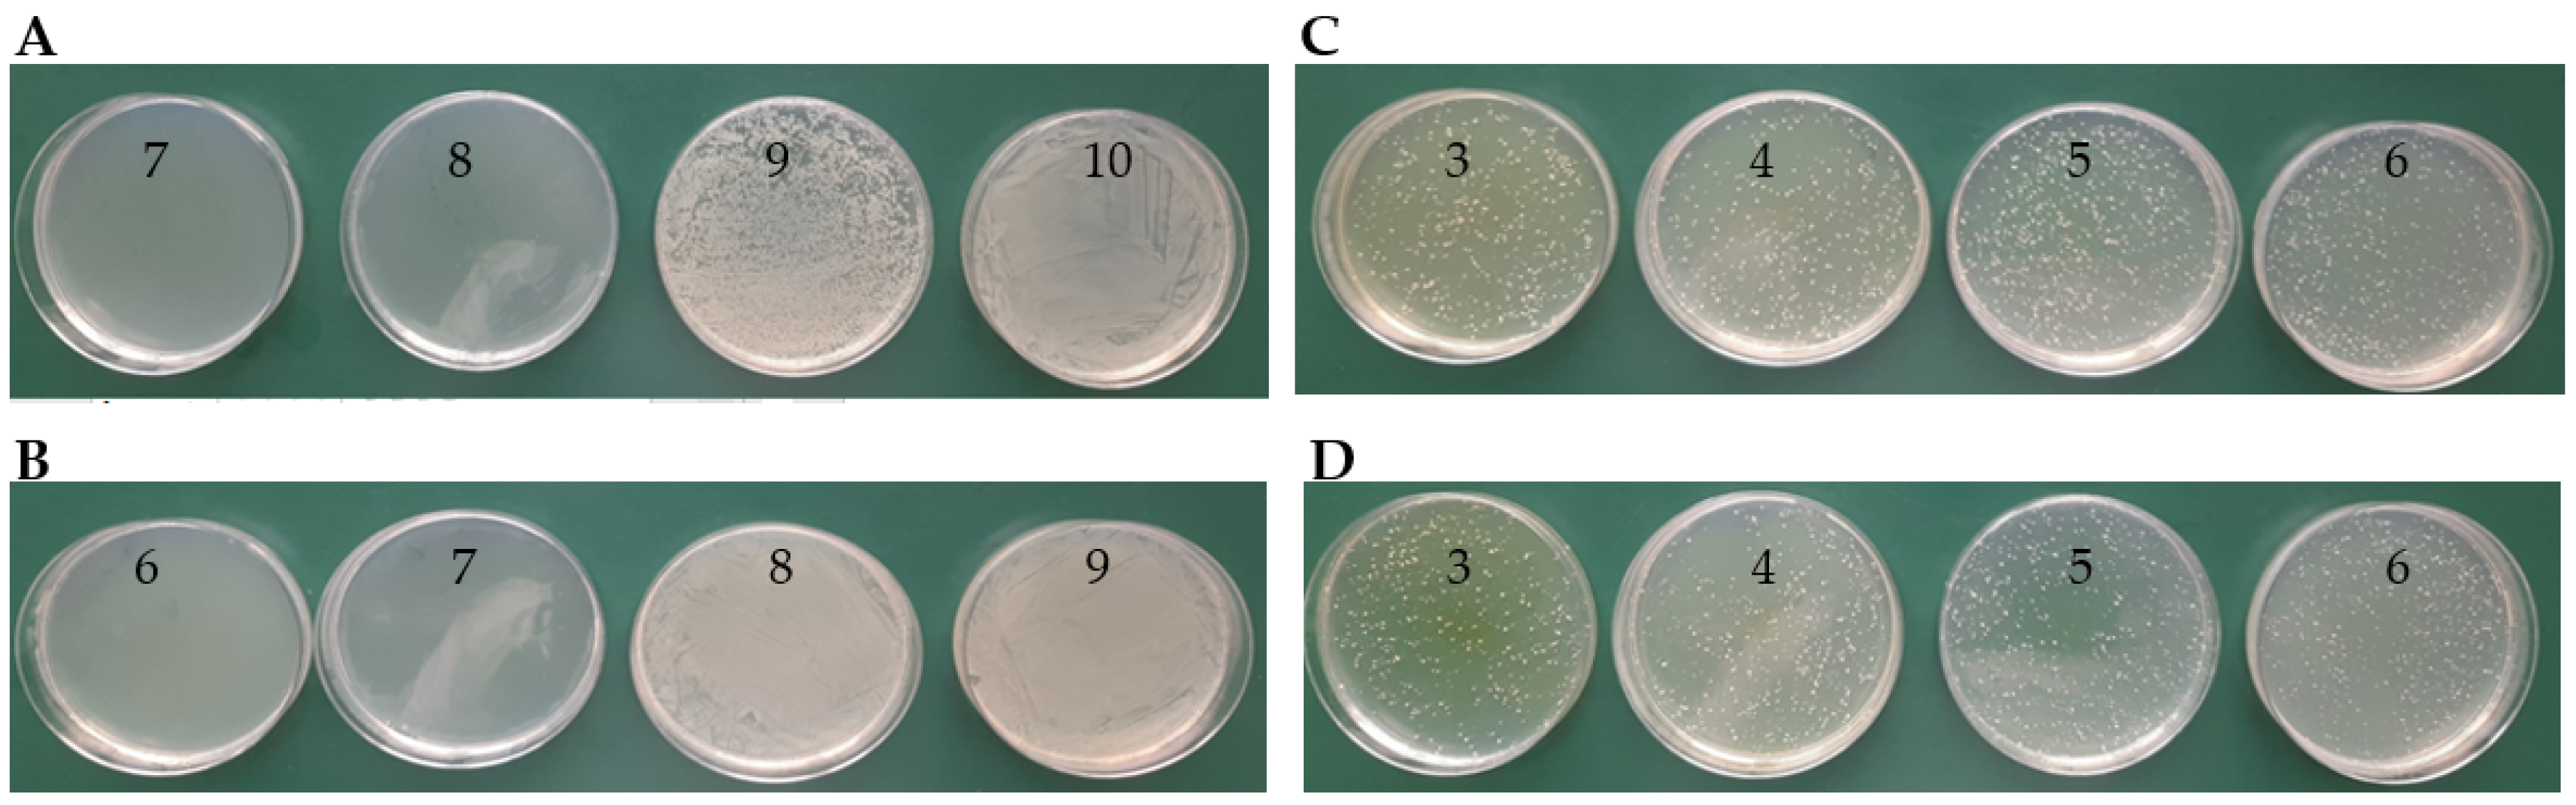
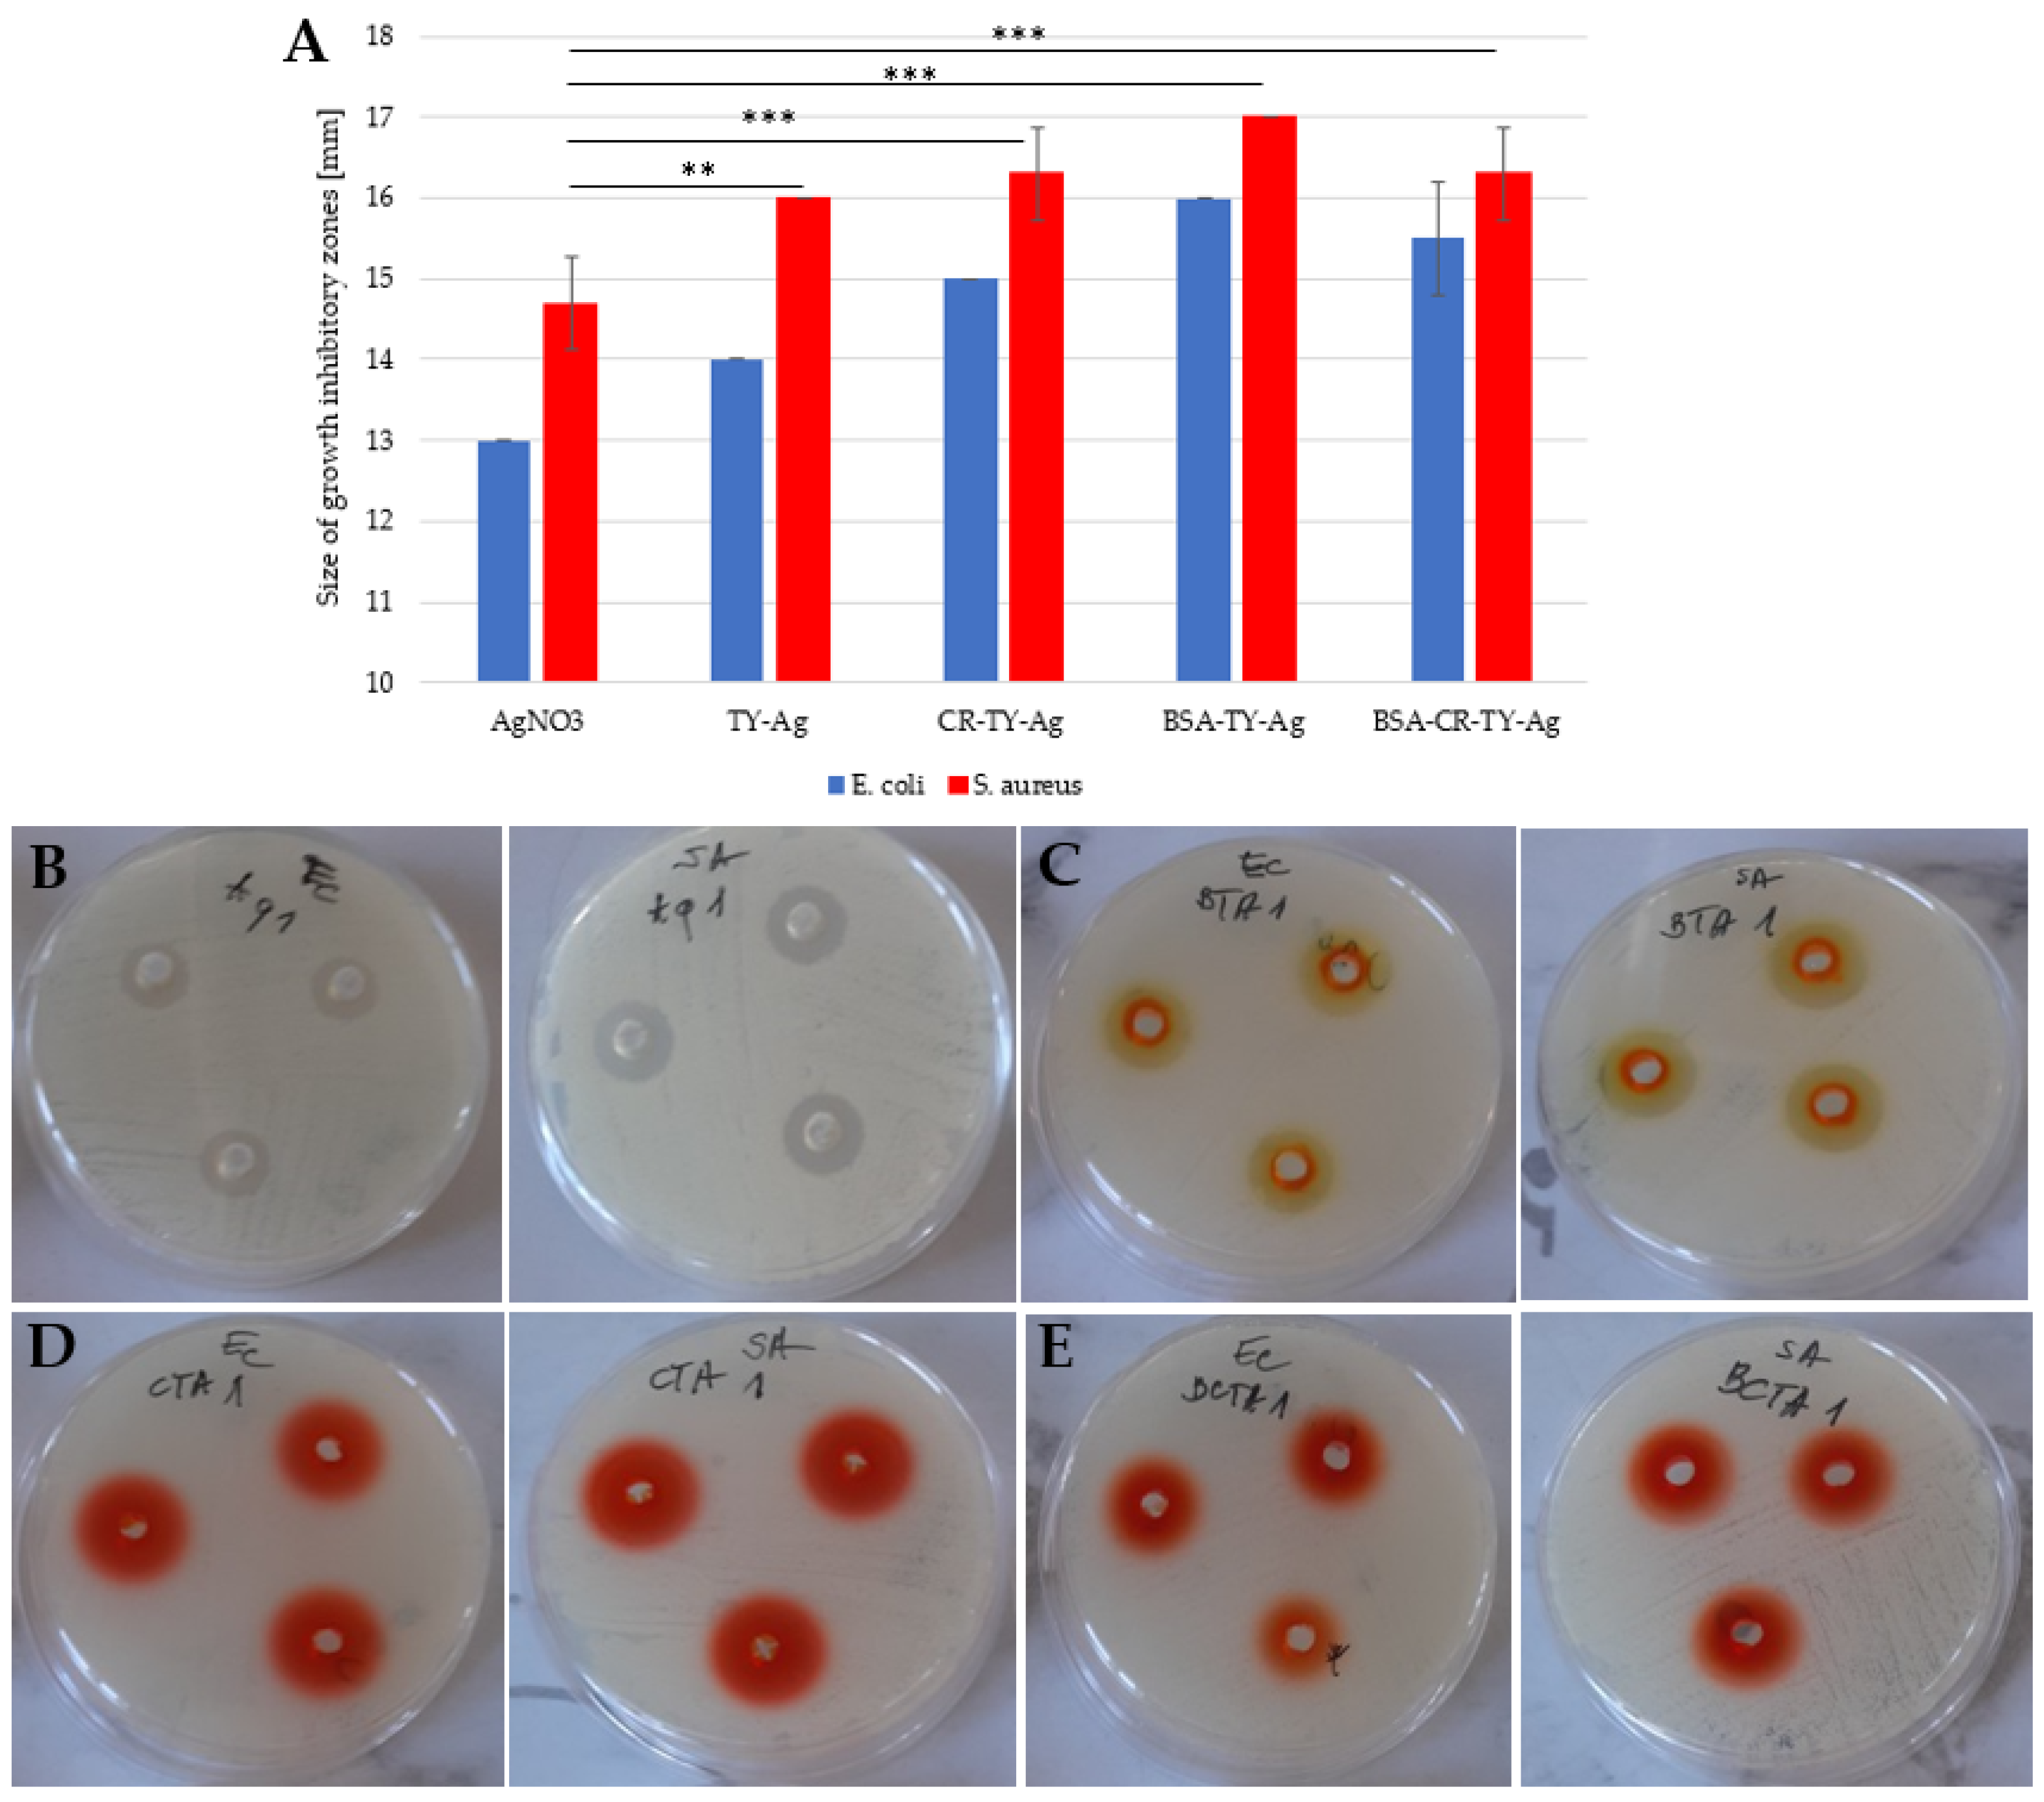

Antibacterial Therapy by Ag+ Ions Complexed with Titan Yellow/Congo Red and Albumin during Anticancer Therapy of Urinary Bladder Cancer
Abstract
1. Introduction
2. Results
2.1. Characterization of TY-Ag Complexes with Protein (BSA-TY-Ag, BSA-CR-TY-Ag)
2.1.1. TY-Ag Complexes with CR and/or BSA in the Optimal Molar Ratio of TY-Ag = 1:0.5 (Agarose Gel Electrophoresis)
2.1.2. Albumin Complexes with TY and TY-Ag (UV/VIS Spectrophotometry)
2.1.3. Albumin Complexes with TY and TY-Ag (Gel-filtration Chromatography on BioGel P-150)
2.1.4. Increase in Size of the TY-Ag Complex as Compared to free TY and Increase in Size of the TY-Ag Bound to Albumin (DLS Assays)
2.2. Microbiological Analysis
2.2.1. No Inhibition of Bacterial Growth by free TY and Enhanced Inhibition of Bacterial Growth upon Complexation of TY with Ag+. Escherichia coli (EC, ATCC® 35218™) and Staphylococcus aureus (SA, ATCC® 29213™)
2.2.2. Determination of the Minimum Inhibitory Concentration (MIC) Value
2.2.3. Determination of the Minimal Bacterial Concentration (MBC) Value
2.2.4. Increasing the Solubility of TY-Ag after Applying CR and/or BSA and Providing Protection, Improving the Antimicrobial Activity of Silver, as Shown by the Example of E. coli and S. aureus
2.3. Cell Analysis
2.3.1. Reduction of T24 Cell Proliferation and Viability under the Influence of Ag+ Complexed with TY (TY-Ag) Similarly to BSA-TY-Ag (Visible Protective Role of Albumin)
2.3.2. Induction of Caspase-3 Activation in T24 Cells by TY-Ag
2.3.3. Induction of Apoptosis in T24 Cells by TY-Ag (Flow Cytometry)
2.3.4. Reduction of T24 Cell Migration by TY-Ag (Scratch Assay)
2.3.5. Increasing the Number of Cells in the G1 Phase and Reducing the Number of Cells in the S and G2 Phase in T24 Cells under the Influence of the Tested Compounds: TY, TY-Ag, BSA-TY and BSA-TY-Ag (Flow Cytometry/Cell Cycle Analysis)
3. Discussion
4. Materials and Methods
4.1. Materials
4.2. Methods
4.2.1. Synthesis of Silver Complexes with TY (TY-Ag), with Congo Red (CR-TY-Ag), with Albumin (BSA-TY-Ag), or with Albumin and Congo Red (BSA-CR-TY-Ag)
4.2.2. Characterization of TY-Ag Complexes with Protein or with CR (BSA-TY-Ag, BSA-CR-TY-Ag)
- Electrophoresis
- Assessment of TY and TY-Ag binding by BSA—Spectrophotometry
- Assessment of TY and TY-Ag binding by BSA - Gel filtration Chromatography
- DLS
4.2.3. Antibacterial Assays
- Microorganisms
- MIC determination. Well Diffusion in agar. Assay and growth conditions
- MBC determination
4.2.4. Cytotoxicity Assays
- Cell Culture
- Treatments of the Cells
- Cell Proliferation Assays
- Cell Survival Analysis
- Scratch Assay
- Cell Cycle Assay
5. Conclusions
Author Contributions
Funding
Institutional Review Board Statement
Informed Consent Statement
Data Availability Statement
Acknowledgments
Conflicts of Interest
References
- World Health Organisation (WHO). Antibiotic Resistance: Multi-Country Public Awareness Survey; WHO: Geneva, Switzerland, 2015. [Google Scholar]
- World Health Organisation (WHO). Antimicrobial Resistance: Global Report on Surveillance; WHO: Geneva, Switzerland, 2014. [Google Scholar]
- Vogel, G. Meet WHO’s dirty dozen: The 12 bacteria for which new drugs are most urgently needed. Science 2017, 354, 6328. [Google Scholar] [CrossRef]
- Taconelli, E.; Margini, N. Global Priority List of Antibiotic-Resistant Bacteria to Guide Research, Discovery, and Development of New Antibiotics; WHO: Geneva, Switzerland, 2017. [Google Scholar]
- Willyard, C. The drug-resistant bacteria that pose the greatest health threats. Nat. Cell Biol. 2017, 543, 15. [Google Scholar] [CrossRef] [PubMed]
- European Centre for Disease Prevention and Control. In Summary of the Latest Data on Antibiotic Resistance in the European Union; ECDC: Stockholm, Sweden, 2016.
- Murray, P.R.; Rosenthal, K.S.; Pfaller, M.A. Medical Microbiology, 8th ed.; Elsevier: Amsterdam, The Netherlands, 2016. [Google Scholar]
- Hopkins, A.M.; Kichenadasse, G.; Karapetis, C.S.; Rowland, A.; Sorich, M. Concomitant Antibiotic Use and Survival in Urothelial Carcinoma Treated with Atezolizumab. Eur. Urol. 2020, 78, 540–543. [Google Scholar] [CrossRef]
- Kamat, A.M.; Hahn, N.M.; Efstathiou, J.A.; Lerner, S.P.; Malmström, P.-U.; Choi, W.; Guo, C.C.; Lotan, Y.; Kassouf, W. Bladder cancer. Lancet 2016, 388, 2796–2810. [Google Scholar] [CrossRef]
- Babjuk, M.; Böhle, A.; Burger, M.; Capoun, O.; Cohen, D.; Compérat, E.M.; Hernández, V.; Kaasinen, E.; Palou, J.; Rouprêt, M.; et al. EAU Guidelines on Non–Muscle-invasive Urothelial Carcinoma of the Bladder: Update. Eur. Urol. 2017, 71, 447–461. [Google Scholar] [CrossRef] [PubMed]
- Kaseb, H.; Aeddula, N.R. Bladder Cancer; StatPearls Publishing: Treasure Island, FL, USA, 2021. [Google Scholar]
- Ainsworth, C. Microbiome: A bag of surprises. Nat. Cell Biol. 2017, 551, S40–S41. [Google Scholar] [CrossRef]
- Ba, M.; Cui, S.; Long, H.; Gong, Y.; Wu, Y.; Lin, K.; Tu, Y.; Zhang, B.; Wu, W. Development of a high-precision bladder hyperthermic intracavitary chemotherapy device for bladder cancer and pharmacokinetic study. BMC Urol. 2019, 19, 126. [Google Scholar] [CrossRef]
- Wang, K.K.; Stone, L.K.; Lieberman, T.D.; Shavit, M.; Baasov, T.; Kishony, R. A Hybrid Drug Limits Resistance by Evading the Action of the Multiple Antibiotic Resistance Pathway. Mol. Biol. Evol. 2015, 33, 492–500. [Google Scholar] [CrossRef][Green Version]
- Natkaniec, J.; Jagusiak, A.; Rybarska, J.; Gosiewski, T.; Kaszuba-Zwoińska, J.; Bulanda, M. Supramolecular Structures as Carrier Systems Enabling the Use of Metal Ions in Antibacterial Therapy. In Self-Assembled Molecules—New Kind of Protein Ligands: Supramolecular Ligands, 1st ed.; Roterman, I., Konieczny, L., Eds.; Springer International Publishing: New York, NY, USA, 2008; Volume 1, pp. 21–42. [Google Scholar]
- Klueh, U.; Wagner, V.; Kelly, S.; Johnson, A.; Bryers, J.D. Efficacy of silver-coated fabric to prevent bacterial colonization and subsequent device-based biofilm formation. J. Biomed. Mater. Res. 2000, 53, 621–631. [Google Scholar] [CrossRef]
- Rai, M.; Deshmukh, S.; Ingle, A.; Gade, A. Silver nanoparticles: The powerful nanoweapon against multidrug-resistant bacteria. J. Appl. Microbiol. 2012, 112, 841–852. [Google Scholar] [CrossRef]
- Steuber, J.; Krebs, W.; Dimroth, P. The Na+-translocating NADH:ubiquinone oxidoreductase from Vibrio alginolyticus—redox states of the FAD prosthetic group and mechanism of Ag+ inhibition. JBIC J. Biol. Inorg. Chem. 1997, 249, 770–776. [Google Scholar] [CrossRef] [PubMed]
- Jagusiak, A.; Chłopaś, K.; Zemanek, G.; Jemioła-Rzemińska, M.; Piekarska, B.; Stopa, B.; Pańczyk, T. Self-Assembled Supramolecular Ribbon-Like Structures Complexed to Single Walled Carbon Nanotubes as Possible Anticancer Drug Delivery Systems. Int. J. Mol. Sci. 2019, 20, 2064. [Google Scholar] [CrossRef]
- Inman, B.A.; Longo, T.A.; Ramalingam, S.; Harrison, M.R. Atezolizumab: A PD-L1–Blocking Antibody for Bladder Cancer. Clin. Cancer Res. 2017, 23, 1886–1890. [Google Scholar] [CrossRef]
- Lu, D.; Ni, Z.; Liu, X.; Feng, S.; Dong, X.; Shi, X.; Zhai, J.; Mai, S.; Jiang, J.; Wang, Z.; et al. Beyond T Cells: Understanding the Role of PD-1/PD-L1 in Tumor-Associated Macrophages. J. Immunol. Res. 2019, 2019, 1919082. [Google Scholar] [CrossRef]
- Lok, C.N.; Ho, C.M.; Chen, R.; He, Q.Y.; Yu, W.Y.; Sun, H.; Tam, P.K.H.; Chiu, J.F.; Che, C.M. Proteomic Analysis of the Mode of Antibacterial Action of Silver Nanoparticles. J. Proteome Res. 2006, 5, 916–924. [Google Scholar] [CrossRef] [PubMed]
- Zhao, G.; Stevens, J.S.E. Multiple parameters for the comprehensive evaluation of the susceptibility of Escherichia coli to the silver ion. BioMetals 1998, 11, 27–32. [Google Scholar] [CrossRef]
- Foxman, B. Urinary Tract Infection Syndromes: Occurrence, recurrence, bacteriology, risk factors, and disease burden. Infect. Dis. Clin. N. Am. 2014, 28, 1–13. [Google Scholar] [CrossRef] [PubMed]
- Arpi, M.; Renneberg, J. The Clinical Significance of Staphylococcus aureus Bacteriuria. J. Urol. 1984, 132, 697–700. [Google Scholar] [CrossRef]
- Muder, R.R.; Brennen, C.; Rihs, J.D.; Wagener, M.M.; Obman, A.; Stout, J.E.; Yu, V.L. Isolation of Staphylococcus aureus from the Urinary Tract: Association of Isolation with Symptomatic Urinary Tract Infection and Subsequent Staphylococcal Bacteremia. Clin. Infect. Dis. 2006, 42, 46–50. [Google Scholar] [CrossRef] [PubMed]
- Gao, Y.; Shang, Q.; Li, W.; Guo, W.; Stojadinovic, A.; Mannion, C.; Man, Y.-G.; Chen, T. Antibiotics for cancer treatment: A double-edged sword. J. Cancer 2020, 11, 5135–5149. [Google Scholar] [CrossRef] [PubMed]
- Soo, V.W.C.; Kwan, B.W.; Quezada, H.; Castillo-Juárez, I.; Pérez-Eretza, B.; García-Contreras, S.J.; Martínez-Vázquez, M.; Wood, T.K.; García-Contreras, R. Repurposing of Anticancer Drugs for the Treatment of Bacterial Infections. Curr. Top. Med. Chem. 2017, 17, 1157–1176. [Google Scholar] [CrossRef]
- Xia, D.; Yang, X.; Liu, W.; Shen, F.; Pan, J.; Lin, Y.; Du, N.; Sun, Y.; Xi, X. Over-expression of CHAF1A in Epithelial Ovarian Cancer can promote cell proliferation and inhibit cell apoptosis. Biochem. Biophys. Res. Commun. 2017, 486, 191–197. [Google Scholar] [CrossRef] [PubMed]
- Yadav, V.; Talwar, P. Repositioning of fluoroquinolones from antibiotic to anti-cancer agents: An underestimated truth. Biomed. Pharmacother. 2019, 111, 934–946. [Google Scholar] [CrossRef]
- Kamat, A.M.; Lamm, D.L. Antitumor activity of common antibiotics against superficial bladder cancer. Urology 2004, 63, 457–460. [Google Scholar] [CrossRef]
- López-Hernández, D. Letter to the Editor: Use of Antibiotics, Gut Microbiota, and Risk of Type 2 Diabetes: Epigenetics Regulation. J. Clin. Endocrinol. Metab. 2016, 101, L62–L63. [Google Scholar] [CrossRef] [PubMed]
- Rai, M.; Gupta, I.; Ingle, A.P.; Biswas, J.K.; Sinitsyna, O.V. Nanomaterials: What Are They, Why They Cause Ecotoxicity, and How This Can Be Dealt With. In Nanomaterials: Ecotoxicity, Safety, and Public Perception; Springer: Singapore, 2018; pp. 3–18. [Google Scholar] [CrossRef]
- Moraes, G.; Zambom, C.; Siqueira, W. Nanoparticles in Dentistry: A Comprehensive Review. Pharmaceuticals 2021, 14, 752. [Google Scholar] [CrossRef] [PubMed]
- Elechiguerra, J.L.; Burt, J.L.; Morones, J.R.; Camacho-Bragado, A.; Gao, X.; Lara, H.H.; Yacaman, M.J. Interaction of silver nanoparticles with HIV-1. J. Nanobiotechnology 2005, 3, 6. [Google Scholar] [CrossRef]
- Chen, X.; Schluesener, H.J. Nanosilver: A nanoproduct in medical application. Toxicol. Lett. 2008, 176, 1–12. [Google Scholar] [CrossRef]
- Matsumura, Y.; Yoshikata, K.; Kunisaki, S.-I.; Tsuchido, T. Mode of Bactericidal Action of Silver Zeolite and Its Comparison with That of Silver Nitrate. Appl. Environ. Microbiol. 2003, 69, 4278–4281. [Google Scholar] [CrossRef] [PubMed]
- Lok, C.-N.; Ho, C.-M.; Chen, R.; He, Q.-Y.; Yu, W.-Y.; Sun, H.; Tam, P.K.-H.; Chiu, J.-F.; Che, C.-M. Silver nanoparticles: Partial oxidation and antibacterial activities. JBIC J. Biol. Inorg. Chem. 2007, 12, 527–534. [Google Scholar] [CrossRef]
- Doty, R.C.; Tshikhudo, T.R.; Brust, M.; Fernig, D.G. Extremely Stable Water-Soluble Ag Nanoparticles. Chem. Mater. 2005, 17, 4630–4635. [Google Scholar] [CrossRef]
- Ahmad, S.A.; Das, S.S.; Khatoon, A.; Ansari, M.T.; Afzal, M.; Hasnain, S.; Nayak, A.K. Bactericidal activity of silver nanoparticles: A mechanistic review. Mater. Sci. Energy Technol. 2020, 3, 756–769. [Google Scholar] [CrossRef]
- Makkar, S.; Aggarwal, A.; Pasricha, S.; Kapur, I. To evaluate the antibacterial properties of silver nano particle based irrigant as endod ontic root canal irrigant. Int. J. Dent. Health Sci. 2014, 1, 485–492. [Google Scholar]
- Morones, J.R.; Elechiguerra, J.L.; Camacho, A.; Holt, K.; Kouri, J.B.; Ramírez, J.T.; Yacaman, M.J. The bactericidal effect of silver nanoparticles. Nanotechnology 2005, 16, 2346–2353. [Google Scholar] [CrossRef]
- Zhou, Y.; Kong, Y.; Kundu, S.; Cirillo, J.D.; Liang, H. Antibacterial activities of gold and silver nanoparticles against Escherichia coli and bacillus Calmette-Guérin. J. Nanobiotechnology 2012, 10, 19. [Google Scholar] [CrossRef] [PubMed]
- Loo, Y.Y.; Rukayadi, Y.; Nor-Khaizura, M.-A.-R.; Kuan, C.H.; Chieng, B.W.; Nishibuchi, M.; Radu, S. In Vitro Antimicrobial Activity of Green Synthesized Silver Nanoparticles Against Selected Gram-negative Foodborne Pathogens. Front. Microbiol. 2018, 9, 1555. [Google Scholar] [CrossRef]
- Prabhu, S.; Poulose, E.K. Silver nanoparticles: Mechanism of antimicrobial action, synthesis, medical applications, and toxicity effects. Int. Nano Lett. 2012, 2, 32. [Google Scholar] [CrossRef]
- Kwan, Y.P.; Saito, T.; Ibrahim, D.; Al-Hassan, F.M.S.; Oon, C.E.; Chen, Y.; Jothy, S.L.; Kanwar, J.R.; Sasidharan, S. Evaluation of the cytotoxicity, cell-cycle arrest, and apoptotic induction byEuphorbia hirtain MCF-7 breast cancer cells. Pharm. Biol. 2015, 54, 1223–1236. [Google Scholar] [CrossRef] [PubMed]
- Oves, M.; Aslam, M.; Rauf, M.A.; Qayyum, S.; Qari, H.A.; Khan, M.S.; Alam, M.Z.; Tabrez, S.; Pugazhendhi, A.; Ismail, I.M. Antimicrobial and anticancer activities of silver nanoparticles synthesized from the root hair extract of Phoenix dactylifera. Mater. Sci. Eng. C 2018, 89, 429–443. [Google Scholar] [CrossRef]
- Gurunathan, S.; Qasim, M.; Park, C.; Yoo, H.; Kim, J.-H.; Hong, K. Cytotoxic Potential and Molecular Pathway Analysis of Silver Nanoparticles in Human Colon Cancer Cells HCT116. Int. J. Mol. Sci. 2018, 19, 2269. [Google Scholar] [CrossRef] [PubMed]
- Firdhouse, M.J.; Lalitha, P. Biosynthesis of silver nanoparticles using the extract of Alternanthera sessilis—antiproliferative effect against prostate cancer cells. Cancer Nanotechnol. 2013, 4, 137–143. [Google Scholar] [CrossRef]
- Liu, X.; Shan, K.; Shao, X.; Shi, X.; He, Y.; Liu, Z.; Jacob, J.A.; Deng, L. Nanotoxic Effects of Silver Nanoparticles on Normal HEK-293 Cells in Comparison to Cancerous HeLa Cell Line. Int. J. Nanomed. 2021, 16, 753–761. [Google Scholar] [CrossRef]
- Gurunathan, S.; Jeong, J.-K.; Han, J.W.; Zhang, X.-F.; Park, J.H.; Kim, J.-H. Multidimensional effects of biologically synthesized silver nanoparticles in Helicobacter pylori, Helicobacter felis, and human lung (L132) and lung carcinoma A549 cells. Nanoscale Res. Lett. 2015, 10, 35. [Google Scholar] [CrossRef] [PubMed]
- Han, M.H.; Park, C.; Jin, C.-Y.; Kim, G.-Y.; Chang, Y.-C.; Moon, S.-K.; Kim, W.-J.; Choi, Y.H. Apoptosis Induction of Human Bladder Cancer Cells by Sanguinarine through Reactive Oxygen Species-Mediated Up-Regulation of Early Growth Response Gene-1. PLoS ONE 2013, 8, e63425. [Google Scholar] [CrossRef]
- Stensberg, M.C.; Wei, Q.; McLamore, E.S.; Porterfield, D.M.; Wei, A.; Sepúlveda, M.S. Toxicological studies on silver nanoparticles: Challenges and opportunities in assessment, monitoring and imaging. Nanomedicine 2011, 6, 879–898. [Google Scholar] [CrossRef] [PubMed]
- Smilowitz, H.M.; Tarmu, L.J.; Sanders, M.M.; Iii, J.A.T.; Choudhary, D.; Xue, C.A.; Dyment, N.; Sasso, D.; Deng, X.; Hainfeld, J.F. Biodistribution of gold nanoparticles in BBN-induced muscle-invasive bladder cancer in mice. Int. J. Nanomed. 2017, 12, 7937–7946. [Google Scholar] [CrossRef] [PubMed]
- Hosseini, S.H.; Rahmani-Sani, A.; Jalalabadi, Y.; Karimzadeh, M.; Hosseini-Bandegharaei, A.; Kharghani, K.; Allahabadi, A. Preconcentration and determination of ultra-trace amounts of U(VI) and Th(IV) using titan yellow-impregnated Amberlite XAD-7 resin. Int. J. Environ. Anal. Chem. 2015, 95, 277–290. [Google Scholar] [CrossRef]
- King, H.G.C.; Pruden, G. The component of commercial Titan yellow most reactive towards magnesium: Its isolation and use in determining magnesium in silicate minerals. Analyst 1967, 92, 83–90. [Google Scholar] [CrossRef]
- Ritz, S.; Schöttler, S.; Kotman, N.; Baier, G.; Musyanovych, A.; Kuharev, J.; Landfester, K.; Schild, H.; Jahn, O.; Tenzer, S.; et al. Protein Corona of Nanoparticles: Distinct Proteins Regulate the Cellular Uptake. Biomacromolecules 2015, 16, 1311–1321. [Google Scholar] [CrossRef]
- Boehmler, D.J.; O’Dell, Z.; Chung, C.; Riley, K.R. Bovine Serum Albumin Enhances Silver Nanoparticle Dissolution Kinetics in a Size- and Concentration-Dependent Manner. Langmuir 2020, 36, 1053–1061. [Google Scholar] [CrossRef]
- Kennedy, D.C.; Qian, H.; Gies, V.; Yang, L. Human serum albumin stabilizes aqueous silver nanoparticle suspensions and inhibits particle uptake by cells. Environ. Sci. Nano 2018, 5, 863–867. [Google Scholar] [CrossRef]
- Buszewski, B.; Rogowska, A.; Railean-Plugaru, V.; Złoch, M.; Walczak-Skierska, J.; Pomastowski, P. The Influence of Different Forms of Silver on Selected Pathogenic Bacteria. Materials 2020, 13, 2403. [Google Scholar] [CrossRef] [PubMed]
- Panzarini, E.; Mariano, S.; Carata, E.; Mura, F.; Rossi, M.; Dini, L. Intracellular Transport of Silver and Gold Nanoparticles and Biological Responses: An Update. Int. J. Mol. Sci. 2018, 19, 1305. [Google Scholar] [CrossRef] [PubMed]
- Wu, M.; Guo, H.; Liu, L.; Liu, Y.; Xie, L. Size-dependent cellular uptake and localization profiles of silver nanoparticles. Int. J. Nanomed. 2019, ume 14, 4247–4259. [Google Scholar] [CrossRef]
- Wypij, M.; Jędrzejewski, T.; Trzcińska-Wencel, J.; Ostrowski, M.; Rai, M.; Golińska, P. Green Synthesized Silver Nanoparticles: Antibacterial and Anticancer Activities, Biocompatibility, and Analyses of Surface-Attached Proteins. Front. Microbiol. 2021, 12, 632505. [Google Scholar] [CrossRef] [PubMed]
- Zhang, S.; Gao, H.; Bao, G. Physical Principles of Nanoparticle Cellular Endocytosis. ACS Nano 2015, 9, 8655–8671. [Google Scholar] [CrossRef] [PubMed]
- Tang, L.; Yang, X.; Yin, Q.; Cai, K.; Wang, H.; Chaudhury, I.; Yao, C.; Zhou, Q.; Kwon, M.; Hartman, J.A.; et al. Investigating the optimal size of anticancer nanomedicine. Proc. Natl. Acad. Sci. USA 2014, 111, 15344–15349. [Google Scholar] [CrossRef] [PubMed]
- Nunez, N.V.A.; Villegas, H.H.L.; Turrent, L.D.C.I.; Padilla, C.R. Silver Nanoparticles Toxicity and Bactericidal Effect Against Methicillin-Resistant Staphylococcus aureus: Nanoscale Does Matter. NanoBiotechnology 2009, 5, 2–9. [Google Scholar] [CrossRef]
- Agnihotri, S.; Mukherji, S.; Mukherji, S. Size-controlled silver nanoparticles synthesized over the range 5–100 nm using the same protocol and their antibacterial efficacy. RSC Adv. 2014, 4, 3974–3983. [Google Scholar] [CrossRef]
- Rathod, D.; Golinska, P.; Wypij, M.; Dahm, H.; Rai, M. A new report of Nocardiopsis valliformis strain OT1 from alkaline Lonar crater of India and its use in synthesis of silver nanoparticles with special reference to evaluation of antibacterial activity and cytotoxicity. Med. Microbiol. Immunol. 2016, 205, 435–447. [Google Scholar] [CrossRef] [PubMed]
- Qing, Y.; Cheng, L.; Li, R.; Liu, G.; Zhang, Y.; Tang, X.; Wang, J.; Liu, H.; Qin, Y. Potential antibacterial mechanism of silver nanoparticles and the optimization of orthopedic implants by advanced modification technologies. Int. J. Nanomed. 2018, 13, 3311–3327. [Google Scholar] [CrossRef]
- Devagi, P.; Suresh, T.C.; Sandhiya, R.V.; Sairandhry, M.; Bharathi, S.; Velmurugan, P.; Radhakrishnan, M.; Sathiamoorthi, T.; Suresh, G. Actinobacterial-Mediated Fabrication of Silver Nanoparticles and Their Broad Spectrum Antibacterial Activity Against Clinical Pathogens. J. Nanosci. Nanotechnol. 2020, 20, 2902–2910. [Google Scholar] [CrossRef] [PubMed]
- Prakasham, R.S.; Kumar, B.S.; Kumar, Y.S.; Kumar, K.P. Production and Characterization of Protein Encapsulated Silver Nanoparticles by Marine Isolate Streptomyces parvulus SSNP11. Indian J. Microbiol. 2014, 54, 329–336. [Google Scholar] [CrossRef]
- Wypij, M.; Czarnecka, J.; Dahm, H.; Rai, M.; Golinska, P. Silver nanoparticles from Pilimelia columellifera subsp. pallida SL19 strain demonstrated antifungal activity against fungi causing superficial mycoses. J. Basic Microbiol. 2017, 57, 793–800. [Google Scholar] [CrossRef]
- Dayma, P.B.; Mangrola, A.V.; Suriyaraj, S.P.; Dudhagara, P.; Patel, R.K. Synthesis of bio-silver nanoparticles using desert isolated Streptomyces intermedius and its antimicrobial activity. J. Pharm. Chem. Biol. Sci. 2019, 7, 94–101. [Google Scholar]
- Bakhtiari-Sardari, A.; Mashreghi, M.; Eshghi, H.; Behnam-Rasouli, F.; Lashani, E.; Shahnavaz, B. Comparative evaluation of silver nanoparticles biosynthesis by two cold-tolerant Streptomyces strains and their biological activities. Biotechnol. Lett. 2020, 42, 1985–1999. [Google Scholar] [CrossRef] [PubMed]
- Składanowski, M.; Golinska, P.; Rudnicka, K.; Dahm, H.; Rai, M. Evaluation of cytotoxicity, immune compatibility and antibacterial activity of biogenic silver nanoparticles. Med. Microbiol. Immunol. 2016, 205, 603–613. [Google Scholar] [CrossRef] [PubMed]
- Hossain, M.M.; Polash, S.A.; Takikawa, M.; Shubhra, R.D.; Saha, T.; Islam, Z.; Hossain, S.; Hasan, M.A.; Takeoka, S.; Sarker, S.R. Investigation of the Antibacterial Activity and in vivo Cytotoxicity of Biogenic Silver Nanoparticles as Potent Therapeutics. Front. Bioeng. Biotechnol. 2019, 7, 239. [Google Scholar] [CrossRef] [PubMed]
- Murei, A.; Pillay, K.; Govender, P.; Thovhogi, N.; Gitari, W.; Samie, A. Synthesis, Characterization and In Vitro Antibacterial Evaluation of Pyrenacantha grandiflora Conjugated Silver Nanoparticles. Nanomaterials 2021, 11, 1568. [Google Scholar] [CrossRef] [PubMed]
- Sonawnae, A.; Jena, P.; Mohanty, S.; Mallick, R.; Jacob, B. Toxicity and antibacterial assessment of chitosan-coated silver nanoparticles on human pathogens and macrophage cells. Int. J. Nanomed. 2012, 7, 1805–1818. [Google Scholar] [CrossRef]
- Biological Evaluation of Medical Devices: Part 1: Evaluation and Testing within a Risk Management Process. ISO 10993-1; ISO: Geneva, Switzerland, 2018.
- Zhou, C.; Wang, G.; Jing, W.; Tan, X.; Guo, H. Anticancer Properties and Mechanisms of Singly-Protonated Dehydronorcantharidin Silver Coordination Polymer in a Bladder Cancer Model. Front. Pharmacol. 2021, 12, 239. [Google Scholar] [CrossRef] [PubMed]
- Gibała, A.; Żeliszewska, P.; Gosiewski, T.; Krawczyk, A.; Duraczyńska, D.; Szaleniec, J.; Szaleniec, M.; Oćwieja, M. Antibacterial and Antifungal Properties of Silver Nanoparticles—Effect of a Surface-Stabilizing Agent. Biomolecules 2021, 11, 1481. [Google Scholar] [CrossRef] [PubMed]
- McCauley, J.; Zivanovic, A.; Skropeta, D. Bioassays for Anticancer Activities. In Methods in Molecular Biology. Springer Science and Business Media LLC: Berlin/Haidelberg, Germany, 2013; Volume 1055, pp. 191–205. [Google Scholar] [CrossRef]
- Lasota, M.; Klein, A.; Balwierz, W. Cytostatic and cytotoxic effects of tyrphostin AG1296 on RMS cells. Współczesna Onkol. 2012, 16, 1–5. [Google Scholar] [CrossRef] [PubMed]
- Bentke, A.; Małecki, J.; Ostrowska, B.; Krzykowska-Petitjean, K.; Laidler, P. Tanespimycin and Tipifarnib Exhibit Synergism in Inducing Apoptosis in Melanoma Cell Lines from Later Stages of Tumor Progression. Cancer Investig. 2013, 31, 545–549. [Google Scholar] [CrossRef]
- Skrzypek, K.; Kusienicka, A.; Szewczyk, B.; Adamus, T.; Lukasiewicz, E.; Miękus, K.; Majka, M. Constitutive activation of MET signaling impairs myogenic differentiation of rhabdomyosarcoma and promotes its development and progression. Oncotarget 2015, 6, 31378–31398. [Google Scholar] [CrossRef] [PubMed]

| No. | TY [mM] | Ag+ [mM] |
|---|---|---|
| 1. | 7.5 | 7.5 |
| 2. | 0.9 | 0.9 |
| 3. | 0.1 | 0.1 |
| 3. | 0.03 | 0.03 |
| Antibacterial Agents | E. coli (EC, ATCC® 35218M) | S. aureus (SA, ATTC® 29213TM) |
|---|---|---|
| TY-Ag (1:0.5) | MIC Ag+: 0.019 mM | MIC Ag+: 0.019 mM |
| BSY-TY-Ag (TY-Ag = 1:0.5; BSA-TY = 1:10) | MIC Ag+: 0.019 mM | MIC Ag+: 0.039 mM |
| Antibacterial Agents | E. coli (EC, ATCC® 35218TM) | S. aureus (SA, ATTC® 29213TM) |
|---|---|---|
| TY-Ag (1:0.5) | MBC Ag+: 0.036 mM | MBC Ag+: above 1.12 mM |
| BSY-TY-Ag (TY-Ag =1:0.5; BSA-TY = 1:10) | MBC Ag+: 0.07 mM | MBC Ag+: above 1.12 mM |
| Ag+ (mM) | TY (mM) | BSA (mM) |
|---|---|---|
| 4.5 | 9 | 0.9 |
| 2.25 | 4.5 | 0.45 |
| 1.12 | 2.25 | 0.22 |
| 0.56 | 1.12 | 0.11 |
| 0.28 | 0.56 | 0.05 |
| 0.14 | 0.28 | 0.03 |
| 0.07 | 0.14 | 0.01 |
| 0.036 | 0.07 | 0.007 |
Publisher’s Note: MDPI stays neutral with regard to jurisdictional claims in published maps and institutional affiliations. |
© 2021 by the authors. Licensee MDPI, Basel, Switzerland. This article is an open access article distributed under the terms and conditions of the Creative Commons Attribution (CC BY) license (https://creativecommons.org/licenses/by/4.0/).
Share and Cite
Jagusiak, A.; Gosiewski, T.; Romaniszyn, D.; Lasota, M.; Wiśniewska, A.; Chłopaś, K.; Ostrowska, B.; Kościk, I.; Bulanda, M. Antibacterial Therapy by Ag+ Ions Complexed with Titan Yellow/Congo Red and Albumin during Anticancer Therapy of Urinary Bladder Cancer. Int. J. Mol. Sci. 2022, 23, 26. https://doi.org/10.3390/ijms23010026
Jagusiak A, Gosiewski T, Romaniszyn D, Lasota M, Wiśniewska A, Chłopaś K, Ostrowska B, Kościk I, Bulanda M. Antibacterial Therapy by Ag+ Ions Complexed with Titan Yellow/Congo Red and Albumin during Anticancer Therapy of Urinary Bladder Cancer. International Journal of Molecular Sciences. 2022; 23(1):26. https://doi.org/10.3390/ijms23010026
Chicago/Turabian StyleJagusiak, Anna, Tomasz Gosiewski, Dorota Romaniszyn, Małgorzata Lasota, Anna Wiśniewska, Katarzyna Chłopaś, Barbara Ostrowska, Izabela Kościk, and Małgorzata Bulanda. 2022. "Antibacterial Therapy by Ag+ Ions Complexed with Titan Yellow/Congo Red and Albumin during Anticancer Therapy of Urinary Bladder Cancer" International Journal of Molecular Sciences 23, no. 1: 26. https://doi.org/10.3390/ijms23010026
APA StyleJagusiak, A., Gosiewski, T., Romaniszyn, D., Lasota, M., Wiśniewska, A., Chłopaś, K., Ostrowska, B., Kościk, I., & Bulanda, M. (2022). Antibacterial Therapy by Ag+ Ions Complexed with Titan Yellow/Congo Red and Albumin during Anticancer Therapy of Urinary Bladder Cancer. International Journal of Molecular Sciences, 23(1), 26. https://doi.org/10.3390/ijms23010026

